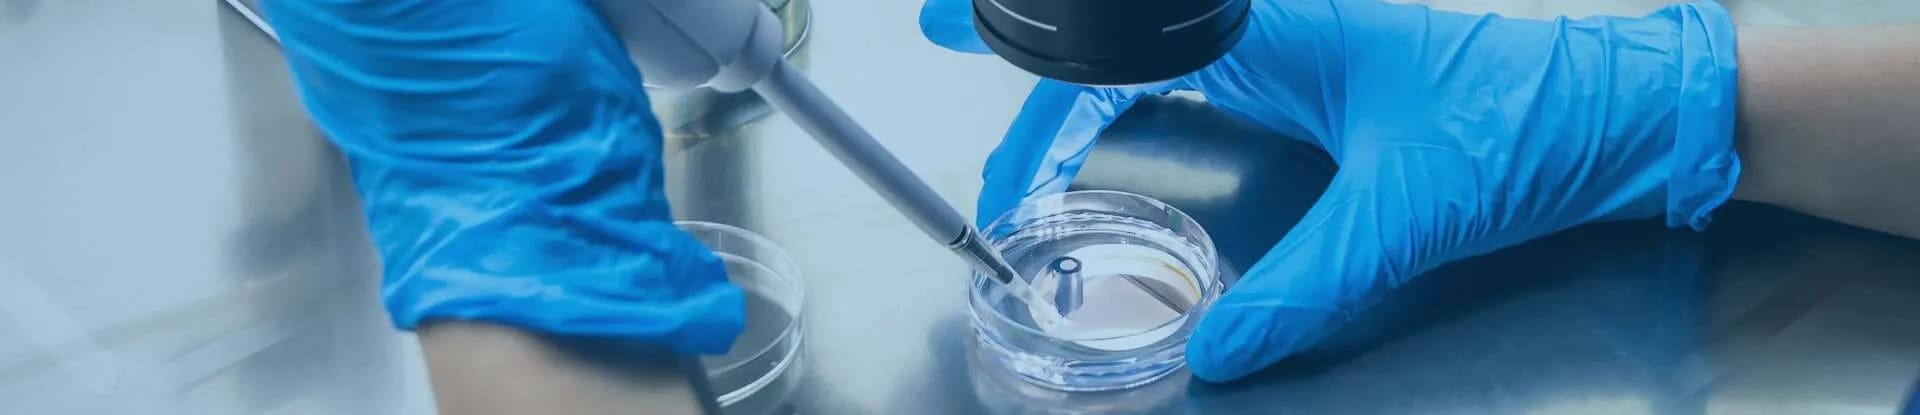
RWD Life Science

-
 Ürünler
Ürünler
-
Ürünler
-
-
 Derin Dondurucular
Derin Dondurucular
-
 Biyogüvenlik Kabinleri
Biyogüvenlik Kabinleri
-
 Santrifüjler
Santrifüjler
-
 Karbondioksitli (CO2) İnkübatörler
Karbondioksitli (CO2) İnkübatörler
-
 Çok Gazlı - CO2 / O2 Kontrollü İnkübatörler
Çok Gazlı - CO2 / O2 Kontrollü İnkübatörler
-
 Soğutmalı İnkübatörler
Soğutmalı İnkübatörler
- İklimlendirme Kabinleri
-
 Laboratuvar Buzdolapları
Laboratuvar Buzdolapları
-
 Kan Saklama Dolapları
Kan Saklama Dolapları
- Otoklavlar ve Buhar Sterilizatörleri
- Laminer Akışlı Kabinler
- PCR Kabini
-
 Hücre Sayım Cihazları
Hücre Sayım Cihazları
- Çeker Ocaklar
-
 Laboratuvar İnkübatörleri
Laboratuvar İnkübatörleri
- İzolatörler
- Anaerobik Ortam Cihazı
- Alev Fotometresi
- Akışkan Yataklı Kurutucu
- Klor Analiz Cihazı - Tuz Analiz Cihazı
- Manyetik Duyarlılık Terazisi - Gouy Terazisi
-
 Mikroplak Çalkalayıcı/İnkübatör
Mikroplak Çalkalayıcı/İnkübatör
- Orbital Çalkalayıcı ve Vortex
-
 Deney Hayvanı Kafesleri
Deney Hayvanı Kafesleri
-
 Deney Hayvanı Üniteleri Cihazları
Deney Hayvanı Üniteleri Cihazları
- Hava Duşu
- Hayvan Çalışma İş İstasyonu
- Titreşim Önleyici Masa
- Biyoreaktör
- Tavan Laminer Hava Akışı Ünitesi
- Aşağı Akış Kabini
- Cam Malzeme Saklama Dolabı
- Pass Box
- Kısıtlı Erişim Bariyer Sistemi
- Havalandırmalı Tartım Kabini
- Plastik Sarf Malzemeler
- Filtreleme ekipman ve sarfları
- Temiz oda ekipman ve sarfları
-
 Yıkama Dezenfeksiyon Makineleri
Yıkama Dezenfeksiyon Makineleri
-
 Sıvı Azot Tankları
Sıvı Azot Tankları
- Hücre Görüntüleme ve Analiz Cihazları
- Isıtıcı- Soğutucu Blok
- Isıtıcılı Kapatıcı - Sealer
- Manyetik Karıştırıcı
- Hız Kontrollü Dondurucu
- Swablar / Eküvyonlar
- Elektroporasyon Sistemleri
- Sperm Sayım ve Analiz
- Doku Saklama Kapları ve Torbaları
-
 Hibridizasyon İnkbatörleri
Hibridizasyon İnkbatörleri
- Analitik Cihazlar
- Sıvı Azot Silindirleri
- Kromotografi Buzdolapları
Ürünler
-
Derin Dondurucular
- -150 C Kriyojenik Dondurucular
- -86 C ULT Derin Dondurucular
- - 60 C Derin Dondurucular
- - 40 C Derin Dondurucular
- - 30 C Derin Dondurucular
- - 25 C Derin Dondurucular
-
-86 C ULT Derin Dondurucular
- İkiz Koruma Serisi
- Standart Seri
- Enerji Tasarruflu Seri
- Buzlanma Korumalı Seri
- Ultra Düşük Enerji Serisi
-
- 30 C Derin Dondurucular
- Frimed Plazma Dondurucu CV5/PF
- Frimed Plazma Dondurucu CV3/PF
- Frimed -30 Derin Dondurucu AF140BL
- Frimed -30 Derin Dondurucu AF70BL
- Frimed -30 Derin Dondurucu CV6
- Frimed -30 Derin Dondurucu CV5
- Frimed -30 Derin Dondurucu CV4
- Frimed -30 Derin Dondurucu SB10BL
- Frimed -30 Derin Dondurucu CV3
- Haier -30 Derin Dondurucu / DW-30L698
- Haier -30 Derin Dondurucu / DW-30L298J
- Haier -30 Derin Dondurucu / DW-30L528D
- Phcbi -30 Derin Dondurucu / MDF-U731M
- Haier -30 Derin Dondurucu / DW-30L818
- Phcbi -30 Derin Dondurucu / MDF-MU539HL
- Phcbi -30 Derin Dondurucu / MDF-MU339HL
- Phcbi -30 Derin Dondurucu / MDF-437
- Frimed Plazma Dondurucu CV6/PF
Derin Dondurucular
-86 C ULT Derin Dondurucular
Standart Seri -86 Derin Dondurucular / Haier 728 litre
Enerji Tasarruflu Seri / Haier 500 litre
Enerji Tasarruflu Seri / Haier 800 litre
Enerji Tasarruflu Seri / Haier 100 litre
Enerji Tasarruflu Seri / Haier 700 litre
Enerji Tasarruflu Seri / PHCBİ 900 Litre
Enerji Tasarruflu Seri / PHCBİ 700 Litre
Enerji Tasarruflu Seri / PHCBİ 500 Litre
Enerji Tasarruflu Smart Seri / PHCBİ 700 Litre
Enerji Tasarruflu Smart Seri / PHCBİ 500 Litre
Enerji Tasarruflu Seri Yatık Tip / PHCBİ 180 Litre
Enerji Tasarruflu Seri Yatık Tip / PHCBİ 84 Litre
Enerji Tasarruflu Seri
- 30 C Derin Dondurucular
-
Biyogüvenlik Kabinleri
- Class I Biyogüvenlik Kabinleri
- Class II Biyogüvenlik Kabinleri
- Class III Biyogüvenlik Kabinleri
-
Class II Biyogüvenlik Kabinleri
- Haier Class II A2 Standart Seri Biyogüvenlik Kabinleri
- Haier Class II A2 Klasik Seri Biyogüvenlik Kabinleri
- Haier Class II A2 Standart Seri Dual HEPA Biyogüvenlik Kabinleri
- Haier Class II A2 Smart IoT Seri Biyogüvenlik Kabinleri
- Haier Class II A2 Mini Biyogüvenlik Kabini
- Haier Class II A2 NSF Serisi Biyogüvenlik Kabinleri
- Esco Class II A2 AirStream Serisi Biyogüvenlik Kabinleri
- Telstar BiOptima Cyto Serisi
- Telstar BiOptima Serisi
- Telstar Bio II Advance Plus Serisi
Biyogüvenlik Kabinleri
Class II Biyogüvenlik Kabinleri
-
Santrifüjler
- Küçük Santrifüjler
- Mikro Santrifüjler
- Masaüstü Santrifüjler
- Yer Tipi Santrifüjler
- Hücre Yıkayıcılar
- Dual Santrifüjler
-
Masaüstü Santrifüjler
- Hettich ROTINA 420 (havalandırmalı ve soğutmalı) Santrifüj
- Afi Groups ISA (havalandırmalı ve soğutmalı) Santrifüj
- Afi Groups SIRENA ( soğutmalı) Santrifüj
- Hettich ROTANTA 460 (Havalandırmalı ve soğutmalı) Santrifüj
- Hettich UNIVERSAL 320 (havalandırmalı ve soğutmalı) Santrifüj
- Hettich ROTINA 380 (havalandırmalı ve soğutmalı) Santrifüj
- Hettich ROTOFIX 32A Santrifüj
- Hettich ROTOFIX 46 / 46 H (Havalandırmalı ve ısıtmalı) Santrifüj
Santrifüjler
Masaüstü Santrifüjler
-
Laboratuvar Buzdolapları
- Derin Donduruculu Kit Saklama Dolapları
- İkiz Kompresörlü Kit Saklama Dolapları
- Standart Kit Saklama Dolapları
- Sürgülü Kapılı Kit Saklama Dolapları
-
Derin Donduruculu Kit Saklama Dolapları
- Phcbi Derin Donduruculu Kit Saklama Dolabı MPR-N250FH
- PHCBI Derin Donduruculu Kit Saklama Dolabı MPR-N450FH
- PHCBI Derin Donduruculu Kit Saklama Dolabı MPR-715F
- Frimed Derin Donduruculu Kit Saklama Dolabı AF70V/2
- Frimed Derin Donduruculu Kit Saklama Dolabı AF140V/2
- Frimed Derin Donduruculu Kit Saklama Dolabı FC39V/2
-
Standart Kit Saklama Dolapları
- PHCBI Kit Saklama Dolabı MPR-722
- PHCBI Kit Saklama Dolabı MPR-1412
- Frimed Kit Saklama Dolabı SB10V
- Frimed Kit Saklama Dolabı FS30V
- Frimed Kit Saklama Dolabı PN45V
- Frimed Kit Saklama Dolabı FS25V
- Frimed Kit Saklama Dolabı PN52V
- Frimed Kit Saklama Dolabı AF70V
- Frimed Kit Saklama Dolabı AF140V
- Haier Kit Saklama Dolabı HYC-761GD
- Haier Kit Saklama Dolabı HYC-130GD /FD
- Haier Kit Saklama Dolabı HYC-1031GDH
- Haier Kit Saklama Dolabı HYC-461GD / FD
- Haier Kit Saklama Dolabı HYC-1030GT
- Haier Kit Saklama Dolabı HYC-85GD / FD
Laboratuvar Buzdolapları
Derin Donduruculu Kit Saklama Dolapları
Standart Kit Saklama Dolapları
-
Çeker Ocaklar
-
Bacalı Çeker Ocaklar
- Esco Frontier® Mono Bacalı Çeker Ocak
- Esco Frontier® Duo- A Serisi Bacalı Çeker Ocak
- Esco Frontier® Acela Bacalı Çeker Ocak
- Esco Frontier® Perklorik Asit Çeker Ocak
- Esco Frontier® Acid Digestion
- Esco Frontier® Acela Mining
- Esco Esco Frontier® Acela™ XP
- Esco Frontier® Floor Mounted
- Esco Frontier® PPH Bacalı Çeker Ocak
-
Bacasız Çeker Ocaklar
- Haier Bacasız Çeker Ocak
- Esco Ascent™ Opti Bacasız Çeker Ocak
- Esco Ascent™ Opti Titramax Bacasız Çeker Ocak
- Esco Powdermax™ Bacasız Çeker Ocak
- Esco Ascent™ Max – B Serisi Bacasız Çeker Ocak
- Esco Ascent™ Max – C Serisi Bacasız Çeker Ocak
- Esco Ascent™ Max – D Serisi Bacasız Çeker Ocak
- Esco Ascent™ Max – E Serisi Bacasız Çeker Ocaklar
Bacalı Çeker Ocaklar
Bacasız Çeker Ocaklar
-
Deney Hayvanı Üniteleri Cihazları
- Maze Sistemleri ve Görüntüleme Yazılımı
- Preklinik Çalışma için Cihazlar
- Farmasötik Araştırma Cihazları
- Konvansiyonel Kafesler ve Ekipmanları
- Metabolik Kafesler
- Laboratuvar Hayvanı Anestezi ve Ventilatör Sistemi
- Dijital Stereotaksik Cihazlar
- Veteriner Lazer Terapi
- Veteriner Yoğun Bakım (ICU) Sistemleri
- Veteriner Dental Çözümler
- Cerrahi Aletler
- İnhalasyon Anestezi Çözümleri
- İnhalasyon Anestezi Cihazları ve Çözümleri
- Mikroenjeksiyon Sistemleri
- Nöral Devre Araştırmaları (Neural Circuit Research)
- Deney Hayvanı Canlı Görüntüleme Sistemleri
- Histoloji ve Patoloji Ürünleri
-
Maze Sistemleri ve Görüntüleme Yazılımı
- Orchid Scientific Barnes Maze
- Orchid Scientific Water Maze
- Orchid Scientific Tail Suspension Test Maze
- Orchid Scientific Light & Dark Box Maze
- Orchid Scientific Yeni Nesne Tanıma Maze
- Orchid Scientific Koşullu Yer Tercihi Kutusu Maze
- Orchid Scientific Elevated Plus Maze
- Orchid Scientific T Maze
- Orchid Scientific Y Maze
- Orchid Scientific Radial Arm Maze
- Orchid Scientific Zero Maze
-
Konvansiyonel Kafesler ve Ekipmanları
- Orchid Scientific Konvansiyonel Fare Kafesleri (Mice Cages)
- Orchid Scientific Konvansiyonel Sıçan Kafesleri (Rat Cages)
- Orchid Scientific Su Besleme Şişeleri (Water Feeding Bottles)
- Orchid Scientific Fare ve Sıçan Kafesi Rafları/Taşıma Arabaları
- Orchid Scientific Fare ve Sıçan Sabitleyiciler (Restrainers)
- Orchid Scientific Üretim Tipi Tavşan Kafesi ve Taşıma Arabası
- Orchid Scientific Entegre Polipropilen Tavşan Kafesli Taşıma Arabası
- Orchid Scientific Tam Ayarlanabilir Akrilik Tavşan Sabitleyici (Rabbit Restrainer)
- Orchid Scientific Paslanmaz Çelik Tavşan Sabitleyici (Rabbit Restrainer)
- Orchid Scientific Hayvan Taşıma Tüpleri (Animal Handling Tubes)
- Orchid Scientific Entegre Polipropilen Kobay (Guinea Pig) Kafesli Taşıma Arabası
- Orchid Scientific Ötanazi Kabini (Euthanasia Chamber)
-
Laboratuvar Hayvanı Anestezi ve Ventilatör Sistemi
- Orchid Scientific Laboratuvar Hayvanları İçin Gaz Anestezi Sistemi
- Orchid Scientific Anestezi ve Ötanazi Sistemi (AES Ultra 01)
- Orchid Scientific Küçük Hayvan Ventilatörü (Model SMV-02)
- RWD Life Science R660 Respiratörlü Anestezi Cihazı
- RWD Life Science R650 Veteriner Anestezi Cihazı
- RWD Life Science R420 Veteriner Elektrikli Turbo Ventilatör
- RWD Life Science RM Serisi Veteriner Monitörleri (RM700, RM800, RM800T)
- RWD Life Science ROC-5A ve ROC-8A Veteriner Oksijen Konsantratörleri
- RWD Life Science RSA Küçük Hayvan Anestezi Cihazı
- RWD Life Science RSV Küçük Evcil Hayvan Ventilatörü
- RWD Life Science Anestezi Hava Pompası (R510 Serisi)
- RWD Life Science R620-MRI Veteriner Anestezi Cihazı
- RWD Life Science R610 Masaüstü Veteriner Anestezi Cihazı
- RWD Life Science R640 Duvara Monte Esnek Veteriner Anestezi Cihazı
- RWD Life Science RM-C1 ve RM-C2 Veteriner Kapnografları
-
Dijital Stereotaksik Cihazlar
- Orchid Scientific Tek Kollu Dijital Stereotaksik Cihaz (Single Arm Digital Stereotaxic Instrument)
- Orchid Scientific Çift Kollu Dijital Stereotaksik Cihaz (Dual Arm Digital Stereotaxic Instrument)
- RWD Life Science 68099Ⅱ Hassas İmpaktör – Travmatik Beyin Hasarı Modelleme Sistemi
- RWD Life Science Taşınabilir Sıçan ve Fare Stereotaksik Cihazı (Portable Stereotaxic Instrument)
- RWD Life Science Masaüstü Dijital Stereotaksik Cihaz
- RWD Life Science Standart Stereotaksik Cihaz
- RWD Life Science Otomatik Stereotaksik Cihaz
- RWD Life Science MR Uyumlu Stereotaksik Cihaz
- RWD Life Science Büyük Hayvan Stereotaksik Cihazları
-
Veteriner Dental Çözümler
- RWD Life Science X5000 CMOS X-Ray Görüntü Sensörü
- RWD Life Science D-X8V Mobil Veteriner Dental X-Ray
- RWD Life Science D-SW Veteriner Ultrasonik Scaler (Diş Taşı Temizleme Cihazı)
- RWD Life Science D-U2000 Esnek Veteriner Diş Ünitesi
- RWD Life Science D-Pro Veteriner Diş Ünitesi
- RWD Life Science D-XV Portatif Veteriner Dental X-Ray
-
Cerrahi Aletler
- RWD Life Science SP0051-C Veteriner Kastrasyon (Kısırlaştırma) Cerrahi Enstrüman Seti
- RWD Life Science SP0050-S Veteriner Sterilizasyon (Dişi Hayvan Kısırlaştırma) Cerrahi Enstrüman Seti
- RWD Life Science DS1005-06 Köpekler İçin Kanatlı Elevatör Seti (Standart Saplı)
- RWD Life Science DS1001-15 Köpekler İçin Kapsamlı Dental Cerrahi Seti
- RWD Life Science DS1010-10 Kediler İçin Dental Cerrahi Seti
- RWD Life Science DS1006-06 Köpekler İçin Kanatlı Elevatör Seti (Kısa / Stubby Saplı),
- RWD Life Science ThermoStar Homeotermik (Vücut Isısı) İzleme ve Isıtma Sistemi
- RWD Life Science LED Fiber Optik Aydınlatıcı
- RWD Life Science 77002 Binoküler Cerrahi Mikroskop
- RWD Life Science 78001 Stereotaksik Mikromatkap
- RWD Life Science 77001S Binoküler Cerrahi Stereomikroskop
-
İnhalasyon Anestezi Cihazları ve Çözümleri
- RWD Life Science Çok Fonksiyonlu Küçük Hayvan İnhalasyon Anestezi Sistemi
- RWD Life Science Hayvan Anestezi ve Stereotaksik Enjeksiyon Çözümleri
- RWD Life Science Küçük Hayvan Anestezi ve Ventilatör Kombinasyon Çözümleri
- RWD Life Science Taiji Küçük Hayvan Anestezi Cihazı
- RWD Life Science R550 Çoklu Çıkışlı Küçük Hayvan Anestezi Sistemi
- RWD Life Science VentStar Küçük Hayvan Ventilatörü
- RWD Life Science R420 Veteriner Elektrikli Turbo Ventilatörü
-
Mikroenjeksiyon Sistemleri
- RWD Life Science MM-500 Motorize Mikromanipülatör
- RWD Life Science R462 Çift Kanallı Şırınga Pompası
- RWD Life Science İmplante Edilebilir Ozmotik Pompalar
- RWD Life Science Laboratuvar Hayvanları İçin Tekli Beyin Kanülü
- RWD Life Science Sıçan ve Fareler İçin Çiftli Beyin Kanülü
- RWD Life Science KDS Legato 130 Şırınga Pompası
- RWD Life Science Küçük Hayvanlar İçin Vasküler İnfüzyon ve Kan Örnekleme Sistemi
- RWD Life Science R-480 Nanolitre Mikroenjeksiyon Pompası
-
Nöral Devre Araştırmaları (Neural Circuit Research)
- RWD Life Science R821 Üç Renkli Çok Kanallı Fiber Fotometri Sistemi
- RWD Life Science Çift Renkli Çok Kanallı Fiber Fotometri Sistemi (R810/R811)
- RWD Life Science R812/FR-12 Çift Renkli Çok Kanallı Fiber Fotometri Sistemi
- RWD Life Science IOS-465 Akıllı Optogenetik Sistemi
- RWD Life Science Yüksek Hassasiyetli Elektrikli ve Manuel Mikromanipülatörler
- RWD Life Science PMP-102 Programlanabilir Yatay Mikropipet Çekici
-
Deney Hayvanı Canlı Görüntüleme Sistemleri
- RWD Life Science Küçük Hayvan In Vivo Görüntüleme Sistemi (Floresan ve Biyolüminesans)
- RWD Life Science RFLSI-ZW Lazer Benek Kontrast Görüntüleme Sistemi (Mikrosirkülasyon Analizi)
- RWD Life Science Yüksek Frekanslı Küçük Hayvan Ultrason Görüntüleme Sistemi
- RWD Life Science Akıllı Olfaktometre (Hassas Koku Stimülasyon Sistemi)
-
Histoloji ve Patoloji Ürünleri
- RWD Life Science FS800A Tam Otomatik Kryostat (Dondurucu Mikrotom)
- RWD Life Science FS800 Serisi Kryostat (Dondurucu Mikrotom)
- RWD Life Science FS-EM Dondurulmuş Kesit Gömme Bileşiği (O.C.T. Compound)
- RWD Life Science S712 Manuel Rotary Mikrotom
- RWD Life Science S710 Tam Otomatik Rotary Mikrotom (Motorize Kesim)
- RWD Life Science S700 Yarı Otomatik Rotary Mikrotom
- RWD Life Science S700A Tam Otomatik Akıllı Rotary Mikrotom
Deney Hayvanı Üniteleri Cihazları
Maze Sistemleri ve Görüntüleme Yazılımı
Konvansiyonel Kafesler ve Ekipmanları
Laboratuvar Hayvanı Anestezi ve Ventilatör Sistemi
Dijital Stereotaksik Cihazlar
Veteriner Dental Çözümler
Cerrahi Aletler
İnhalasyon Anestezi Cihazları ve Çözümleri
Mikroenjeksiyon Sistemleri
Nöral Devre Araştırmaları (Neural Circuit Research)
Deney Hayvanı Canlı Görüntüleme Sistemleri
Histoloji ve Patoloji Ürünleri
-
Yıkama Dezenfeksiyon Makineleri
- Laboratuvar Tipi Cam Malzeme Yıkama Cihazları
- Hastane Tipi Yıkama Dezenfeksiyon Cihazları
- Mop Yıkama Cihazları
- Kafes Yıkama Makineleri
-
Laboratuvar Tipi Cam Malzeme Yıkama Cihazları
- Miele Laboratuvar Tipi Yıkama Makinesi PLW 8604
- Miele Laboratuvar Tipi Yıkama Dezenfeksiyon Makinesi PLW8683
- Miele Laboratuvar Tipi Yıkama Dezenfeksiyon Makinesi PLW8693
- Miele Laboratuvar Tipi Yıkama Dezenfeksiyon Makinesi PLW8683CD
- Miele Laboratuvar Tipi Yıkama Dezenfeksiyon Makinesi PLW7111
- Miele Laboratuvar Tipi Yıkama Dezenfeksiyon Makinesi PLW8616
- Miele Laboratuvar Tipi Yıkama Dezenfeksiyon Makinesi PLW8617
Yıkama Dezenfeksiyon Makineleri
Laboratuvar Tipi Cam Malzeme Yıkama Cihazları
-
Sıvı Azot Tankları
- Yüksek Kapasiteli Depolama Tankları
- Sıvı Azot Saklama ve Taşıma Tankları
- Kanisterli Tanklar
- Racklı Tanklar
-
Sıvı Azot Saklama ve Taşıma Tankları
- CBS Patentli Buhar Faz LN2 Saklama Tanklari
- IC Biomedical LABS Serisi Biyobanka Örnek Saklama Tankı
- IC Biomedical HC Serisi Yüksek Kapasiteli Kanisterli Örnek Saklama Tankı
- IC Biomedical XT Serisi Kanisterli Örnek Saklama ve Taşıma Tankı
- IC Biomedical LS Serisi Otomatik Dolum Örnek Saklama Tankı
- Haier CryoBio Z Serisi Örnek Saklama Tankı
- Haier Sıvı Azot Konteynırı - Düşük Sıcaklıklı Taşıma Arabası YDC-3000H
- Haier Bio-2T Taşınabilir Kriyojenik Transfer Tankı
Sıvı Azot Tankları
Sıvı Azot Saklama ve Taşıma Tankları
-
-
-
 Uygulama Alanları
Uygulama Alanları
-
Uygulama Alanları
-
-
 Adli Tıp
Adli Tıp
-
 Deney Hayvanları
Deney Hayvanları
-
 Cell Theraphy-GMP/GLP
Cell Theraphy-GMP/GLP
-
 Biyobanka RNA&DNA&Doku
Biyobanka RNA&DNA&Doku
-
 BSL 1 2 3 4 Laboratuvarları
BSL 1 2 3 4 Laboratuvarları
-
 Kemik İliği Transplantasyon
Kemik İliği Transplantasyon
-
 Kordon Kanı Bankacılığı
Kordon Kanı Bankacılığı
-
 IVF-Tüp Bebek
IVF-Tüp Bebek
-
 Kan Bankacılığı
Kan Bankacılığı
-
 Suni Tohumlama/ Veterinerlik
Suni Tohumlama/ Veterinerlik
-
 Hücre Kültürü
Hücre Kültürü
-
 Mikrobiyoloji
Mikrobiyoloji
-
 Klinik Araştırmalar için Ekipmanlar
Klinik Araştırmalar için Ekipmanlar
 Adli Tıp
Adli Tıp Adli tıp, hukuk sistemine bilimsel veriler sunarak adaletin sağlanmasında kritik rol oynar. Suç delillerinin incelenmesi ve analizleri adli tıp laboratuvarlarının uzmanlığıdır.
 Deney Hayvanları
Deney Hayvanları Deney Hayvanları Laboratuvarları İçin Gelişmiş Cihaz Çözümleri: Bilimsel Etiğe Uygun Araştırmalar Deney hayvanları, yeni ilaçların, tedavilerin, aşıların ve cerrahi tekniklerin geliştirilmesinde, biyolojik süreçlerin anlaşılmasında ve hastalık mekanizmalarının aydınlatılmasında vazgeçilmez bir rol oynamaktadır. Bu kritik rol, aynı zamanda deney hayvanları laboratuvarlarının en yüksek bilimsel ve etik standartlarda çalışmasını gerektirir. Hayvan refahının sağlanması, verilerin güvenilirliği ve araştırmaların tekrarlanabilirliği, bu laboratuvarların temel öncelikleridir. Şirketiniz, bu hassas ve düzenlemelere tabi alandaki laboratuvarların ihtiyaç duyduğu yüksek teknolojili laboratuvar cihazları ve entegre çözümler sunarak, bilimsel araştırmalarınıza etik ve güvenilir bir temel sağlamaktadır.
 Cell Theraphy-GMP/GLP
Cell Theraphy-GMP/GLP Hücre Terapisi ve GMP/GLP Laboratuvarları İçin İleri Cihaz Çözümleri: Güvenlikten Tedaviye Hücre ve gen terapileri, otolog (hastanın kendi hücrelerinden) veya allojenik (donör hücrelerinden) yaklaşımlarla, kanserden genetik hastalıklara kadar geniş bir yelpazede yenilikçi tedavi seçenekleri sunmaktadır. Bu tedavilerin geliştirilmesi ve üretimi, insan sağlığı için en yüksek güvenlik, etkinlik ve kalite standartlarını gerektirir. Hücre terapisi laboratuvarları, araştırma ve geliştirmeden klinik uygulamaya kadar tüm süreçlerde İyi Üretim Uygulamaları (GMP) ve İyi Laboratuvar Uygulamaları (GLP) prensiplerine sıkı sıkıya bağlı kalmak zorundadır. Labor İldam, bu son derece düzenlenmiş ve teknik olarak zorlu alandaki laboratuvarların ihtiyaç duyduğu yüksek teknolojili, valide edilebilir ve uyumlu laboratuvar cihazları ve entegre çözümler sunarak, güvenli ve etkili hücre terapilerinin hastalarla buluşmasına destek olmaktadır.
 Biyobanka RNA&DNA&Doku
Biyobanka RNA&DNA&Doku Biyobanka (RNA, DNA, Doku) Laboratuvarları İçin İleri Cihaz Çözümleri: Örnek Bütünlüğünden Bilimsel Keşfe Biyobankalar, modern biyomedikal araştırmaların ve kişiselleştirilmiş tıbbın temelini oluşturan paha biçilmez kaynaklardır. Hastalıkların nedenlerini anlamaktan yeni tanı yöntemleri ve tedaviler geliştirmeye kadar geniş bir yelpazede, yüksek kaliteli biyolojik örneklere (RNA, DNA, doku, kan, plazma vb.) erişim kritik öneme sahiptir. Bu örneklerin toplanması, işlenmesi, uzun süreli depolanması ve dağıtımı, örnek bütünlüğünü, izlenebilirliği ve veri güvenliğini en üst düzeyde tutan biyobanka laboratuvarlarının uzmanlığını gerektirir. Şirketimiz, bu son derece hassas ve düzenlemelere tabi alandaki laboratuvarların ihtiyaç duyduğu yüksek teknolojili, güvenilir ve otomatize edilmiş laboratuvar cihazları ve entegre çözümler sunarak, değerli biyolojik kaynaklarınızın korunmasına ve bilimsel keşiflere dönüştürülmesine destek olmaktadır.
 BSL 1 2 3 4 Laboratuvarları
BSL 1 2 3 4 Laboratuvarları BSL 1, 2, 3 ve 4 Laboratuvarları İçin İleri Cihaz Çözümleri: Maksimum Güvenlik, Minimum Risk Biyolojik araştırmalar ve tanısal çalışmalar, insan sağlığı ve toplum güvenliği için vazgeçilmezdir. Ancak, bu çalışmalar sırasında karşılaşılabilecek potansiyel biyolojik riskler, laboratuvarların ve çalışanların korunmasını zorunlu kılar. Biyogüvenlik Seviyesi (BSL) laboratuvarları, çalışılan mikroorganizmaların tehlike derecesine göre (Risk Grup 1'den 4'e) sınıflandırılmış, özel olarak tasarlanmış ve donatılmış tesislerdir. BSL-1'den BSL-4'e kadar her seviye, artan bir korunma ve tecrit düzeyi sunar. Şirketimiz, bu katı standartlara uygun, güvenliği ve verimliliği bir arada sunan son teknoloji laboratuvar cihazları ve entegre çözümler sunarak, biyolojik tehlikelerle çalışırken araştırmalarınızın ve operasyonlarınızın güvenliğini en üst düzeye çıkarmanıza yardımcı olur.
 Kemik İliği Transplantasyon
Kemik İliği Transplantasyon Kemik İliği Transplantasyon Laboratuvarları İçin Gelişmiş Cihaz Çözümleri: Umut Veren Tedavilerin Güvencesi Kemik iliği transplantasyonu, hayatı tehdit eden kan hastalıkları, genetik bozukluklar ve bazı kanser türleri için modern tıbbın en etkili tedavi yöntemlerinden biridir. Bu karmaşık ve hassas süreç, donörden kök hücrelerin toplanmasından başlayarak, işlenmesi, saklanması ve hastaya nakledilmesine kadar her aşamada en yüksek sterilite, hassasiyet ve kalite kontrol standartlarını gerektirir. Kemik iliği transplantasyon laboratuvarları, bu yaşamsal tedavilerin başarısı için kritik bir rol oynar. Şirketimiz, bu özel ve düzenlemelere tabi alandaki laboratuvarların ihtiyaç duyduğu son teknoloji, valide edilebilir ve yüksek güvenilirlikli laboratuvar cihazları ve entegre çözümler sunarak, hastalar için umut veren tedavilerin güvencesi olmaktadır. Kemik İliği Transplantasyon Laboratuvarlarındaki Temel Zorluklar ve Çözümlerimiz Kemik iliği transplantasyon laboratuvarları, canlı hücrelerle çalışmanın getirdiği özel zorluklar (hücre canlılığı, kontaminasyon riski) ve katı düzenleyici gerekliliklerle (izlenebilirlik, veri bütünlüğü, GMP/GLP uyumu) başa çıkmak zorundadır
 Kordon Kanı Bankacılığı
Kordon Kanı Bankacılığı Kordon Kanı Bankacılığı Laboratuvarları İçin İleri Cihaz Çözümleri: Geleceğin Sağlığına Yatırım Kordon kanı bankacılığı, hayat kurtarıcı potansiyele sahip kök hücrelerin gelecekteki tedavi ihtiyaçları için saklanmasını sağlayan, hızla gelişen bir alandır. Yeni doğan bebeklerin göbek kordonundan elde edilen bu değerli biyolojik materyal, başta hematolojik ve genetik hastalıklar olmak üzere birçok rahatsızlığın tedavisinde alternatif bir kaynak sunmaktadır. Bu alandaki kordon kanı bankacılığı laboratuvarları, kordon kanının toplanmasından işlenmesine, kalite kontrolünden kriyoprezervasyona kadar her aşamada mutlak sterilite, yüksek hassasiyet ve sıkı düzenleyici uyumluluk (GMP/GTP) gerektirir. Şirketimiz, bu özel ve titizlik gerektiren alandaki laboratuvarların ihtiyaç duyduğu son teknoloji, valide edilebilir ve yüksek güvenilirlikli laboratuvar cihazları ve entegre çözümler sunarak, değerli kök hücre ürünlerinizin bütünlüğünü korumanıza ve geleceğin tedavilerine zemin hazırlamanıza destek olmaktadır.
 IVF-Tüp Bebek
IVF-Tüp Bebek IVF (Tüp Bebek) Laboratuvarları İçin İleri Cihaz Çözümleri: Gelecek Ailelerin Oluşumunda Bilimsel Destek İn vitro fertilizasyon (IVF), yani tüp bebek tedavisi, kısırlıkla mücadele eden milyonlarca çifte ebeveynlik hayallerini gerçekleştirme fırsatı sunan, tıbbın en mucizevi alanlarından biridir. Bu tedavinin başarısı, IVF laboratuvarlarında yürütülen titiz ve hassas süreçlere doğrudan bağlıdır. Yumurta ve sperm hücrelerinin toplanmasından embriyo gelişiminin her aşamasına kadar, her adımda en yüksek sterilite, optimal çevre koşulları ve son teknoloji laboratuvar cihazları kritik öneme sahiptir. Şirketimiz, bu özel ve duyarlı alandaki laboratuvarların ihtiyaç duyduğu yüksek hassasiyetli, güvenilir ve inovatif çözümleri sunarak, geleceğin ailelerinin kurulmasına bilimsel ve teknolojik destek sağlamaktadır.
 Kan Bankacılığı
Kan Bankacılığı Kan Bankacılığı Laboratuvarları İçin İleri Cihaz Çözümleri: Hayat Kurtaran Damlaların Güvencesi Kan, insan hayatı için vazgeçilmez bir kaynaktır ve kan bankacılığı, hastaların cerrahi operasyonlar, travmalar, kronik hastalıklar veya kanser tedavileri sırasında ihtiyaç duyduğu kan ve kan ürünlerine erişimini sağlayan hayati bir hizmettir. Bu kritik süreç, kanın toplanmasından başlayarak, virüs taramalarından kan grubu testlerine, bileşen ayrımından uzun süreli depolamaya kadar her aşamada en yüksek güvenlik, hassasiyet ve kalite kontrol standartlarını gerektirir. Kan bankacılığı laboratuvarları, transfüzyon tıbbının kalbidir ve her damla kanın hastaya güvenle ulaşmasını sağlar. Şirketimiz, bu özel ve düzenlemelere tabi alandaki laboratuvarların ihtiyaç duyduğu son teknoloji, valide edilebilir ve yüksek güvenilirlikli laboratuvar cihazları ve entegre çözümler sunarak, hayat kurtaran transfüzyon hizmetlerinin güvencesi olmaktadır.
 Suni Tohumlama/ Veterinerlik
Suni Tohumlama/ Veterinerlik Suni Tohumlama ve Veterinerlik Laboratuvarları İçin İleri Cihaz Çözümleri: Sağlıklı Hayvanlar, Verimli Üretim Hayvan sağlığı ve verimli hayvancılık, hem gıda güvenliği hem de biyoçeşitliliğin korunması açısından büyük önem taşır. Suni tohumlama, genetik iyileştirmeyi hızlandırarak ve üreme verimliliğini artırarak modern hayvancılığın temelini oluştururken; veterinerlik laboratuvarları ise hayvan hastalıklarının teşhisi, önlenmesi ve tedavisinde, aşı geliştirilmesinde ve genel hayvan refahının sağlanmasında kilit bir rol oynar. Bu dinamik ve çeşitlilik arz eden sektörde, doğru teşhis ve etkili çözümler için son teknoloji laboratuvar cihazlarına ve hassas analitik yöntemlere ihtiyaç duyulur. Şirketimiz, bu özel alandaki laboratuvarların ihtiyaç duyduğu yüksek hassasiyetli, güvenilir ve inovatif çözümleri sunarak, hem hayvan sağlığına hem de sürdürülebilir hayvansal üretime bilimsel destek sağlamaktadır.
 Hücre Kültürü
Hücre Kültürü Hücre Kültürü Laboratuvarları İçin İleri Cihaz Çözümleri: Yaşam Bilimlerinde Temel Taş Hücre kültürü, modern yaşam bilimlerinde ve biyoteknolojide bir köşe taşıdır. Kanser araştırmalarından ilaç keşfine, aşı üretiminden rejeneratif tıbba kadar pek çok alanda, hücrelerin laboratuvar ortamında canlı tutulması, çoğaltılması ve manipüle edilmesi esastır. Bu hassas süreçler, hücrelerin doğal ortamlarını en iyi şekilde taklit eden, kontrollü, steril ve optimize edilmiş koşullar sunan hücre kültürü laboratuvarlarının uzmanlığını ve son teknoloji laboratuvar cihazlarını gerektirir. Labor İldam, bu kritik alandaki laboratuvarların ihtiyaç duyduğu yüksek hassasiyetli, güvenilir ve verimli çözümleri sunarak, araştırmalarınızın doğruluğunu artırmanıza ve bilimsel keşiflerinizi hızlandırmanıza yardımcı olmaktadır.
 Mikrobiyoloji
Mikrobiyoloji Mikrobiyoloji Laboratuvarları İçin İleri Cihaz Çözümleri: Mikroskobik Dünyanın Keşfi Mikrobiyoloji, görünmez dünyanın sırlarını aydınlatarak insan sağlığından çevre korumasına, gıda güvenliğinden endüstriyel süreçlere kadar geniş bir yelpazede çözümler sunar. Bakteriler, virüsler, mantarlar ve diğer mikroorganizmaların incelenmesi, hastalıkların teşhisinden yeni antibiyotiklerin geliştirilmesine kadar her alanda mikrobiyoloji laboratuvarlarının vazgeçilmez uzmanlığını ve son teknoloji laboratuvar cihazlarını gerektirir. Elde edilen her verinin güvenilirliği ve doğruluğu, hem bilimsel ilerleme hem de halk sağlığı açısından kritik öneme sahiptir. Labor İldam, bu dinamik ve titizlik gerektiren alandaki laboratuvarların ihtiyaç duyduğu hassas, güvenilir ve yüksek performanslı analitik çözümleri sunarak, mikrobiyolojik araştırmalarınızın ve operasyonlarınızın başarısına katkı sağlamaktadır.
 Klinik Araştırmalar için Ekipmanlar
Klinik Araştırmalar için Ekipmanlar Klinik Araştırmalar Laboratuvarları İçin İleri Cihaz Çözümleri: Bilimden Hastalara Umut Klinik araştırmalar, bilimsel keşifleri somut tedavi yöntemlerine dönüştüren, insan sağlığını iyileştirmede kritik bir köprü görevi görür. Yeni ilaç adaylarının etkinliğini test etmekten, mevcut tedavilerin güvenliğini doğrulamaya kadar, her adımda klinik araştırmalar laboratuvarlarının titiz ve hassas çalışmaları esastır. Bu laboratuvarlar, hasta örneklerinin toplanmasından, karmaşık analizlere, veri bütünlüğünden katı düzenleyici standartlara (Good Clinical Practice - GCP) uymaya kadar geniş bir yelpazede zorluklarla karşılaşır. Şirketiniz, bu özel ve yüksek sorumluluk gerektiren alandaki laboratuvarların ihtiyaç duyduğu son teknoloji, valide edilebilir ve yüksek güvenilirlikli laboratuvar cihazları ve entegre çözümler sunarak, bilimsel keşiflerinizin güvenli ve etkili tedavilere dönüşmesine katkı sağlamaktadır.
-
-
-
 Sektörler
Sektörler
-
Sektörler
-
-
 Gıda
Gıda
-
 Aşı ve İlaç
Aşı ve İlaç
-
 Biyoteknoloji
Biyoteknoloji
-
 Tarımsal Araştırma Geliştirme (AR-GE)
Tarımsal Araştırma Geliştirme (AR-GE)
-
 Elektronik ve Optik
Elektronik ve Optik
-
 Kozmetik
Kozmetik
-
 Otomotiv
Otomotiv
 Gıda
Gıda Gıda Laboratuvarları İçin Kapsamlı Enstrüman Çözümleri: Güvenlikten Kaliteye Gıda endüstrisi insan sağlığı ve ekonomileri için hayati öneme sahiptir. Tüketiciler için güvenli ve kaliteli gıdaya erişim, üreticilerin sorumluluğunda olduğu kadar bu ürünleri analiz eden gıda laboratuvarlarının da temel görevidir. Gelişen teknolojiler ve artan düzenlemeler, gıda laboratuvarlarını sürekli olarak daha hızlı, daha doğru ve daha güvenilir analiz yöntemleri kullanmaya teşvik etmektedir. Şirketimizin gıda endüstrisindeki laboratuvar profesyonellerinin tüm ihtiyaçlarını karşılayacak yenilikçi laboratuvar enstrümanları ve çözümleri sunduğu yer burasıdır.
 Aşı ve İlaç
Aşı ve İlaç Aşı ve İlaç Laboratuvarları İçin Gelişmiş Cihaz Çözümleri: Araştırmadan Üretime Aşı ve ilaç sektörü, sürekli gelişen bilimsel keşifler ve katı regülasyonlarla şekillenen dinamik bir alandır. İnsan sağlığı için hayati öneme sahip bu ürünlerin geliştirilmesi, üretimi ve kalite kontrolü, ileri teknoloji laboratuvar cihazları ve hassas analiz yöntemleri gerektirir. Labor İldam, bu kritik sektördeki laboratuvarların Ar-Ge aşamasından üretime, kalite kontrolden stabilite çalışmalarına kadar tüm ihtiyaçlarını karşılayacak yenilikçi ve güvenilir laboratuvar ekipmanları sunmaktadır.
 Biyoteknoloji
Biyoteknoloji Biyoteknoloji Laboratuvarları İçin İleri Cihaz Çözümleri: Keşiften Uygulamaya Biyoteknoloji, canlı sistemleri ve biyolojik süreçleri kullanarak ürünler ve teknolojiler geliştiren, çığır açıcı bir bilim dalıdır. Tıp ve eczacılıktan tarıma, enerji üretiminden çevre temizliğine kadar pek çok alanda devrim niteliğinde çözümler sunan biyoteknoloji sektörü, sürekli yenilik ve yüksek hassasiyet gerektiren laboratuvar çalışmalarının merkezindedir. Labor İldam, bu dinamik ve hızla büyüyen alandaki biyoteknoloji laboratuvarlarının ihtiyaç duyduğu son teknoloji laboratuvar cihazları ve entegre çözümler sunarak, araştırmalarınızı hızlandırmanıza, üretim süreçlerinizi optimize etmenize ve çığır açan keşiflere imza atmanıza yardımcı olur.
 Tarımsal Araştırma Geliştirme (AR-GE)
Tarımsal Araştırma Geliştirme (AR-GE) Tarımsal AR-GE Laboratuvarları İçin Gelişmiş Cihaz Çözümleri: Verimlilikten Sürdürülebilirliğe Tarımsal Araştırma ve Geliştirme (AR-GE), dünya nüfusunun artan gıda ihtiyacını karşılama, iklim değişikliğinin etkileriyle mücadele etme ve sürdürülebilir tarım uygulamalarını geliştirme misyonuyla hayati bir rol oynamaktadır. Modern tarımsal AR-GE laboratuvarları; toprak analizlerinden bitki genetiğine, ürün kalitesinden çevresel izlemeye kadar geniş bir yelpazede analizler yaparak, tarımsal üretimin verimliliğini ve kalitesini artırmayı hedefler. Labor İldam, bu dinamik sektördeki laboratuvarların ihtiyaç duyduğu yüksek teknolojili laboratuvar cihazları ve entegre çözümler sunarak, tarımsal araştırmalarınıza bilimsel destek sağlamaktadır.
 Elektronik ve Optik
Elektronik ve Optik Elektronik ve Optik Laboratuvarları İçin İleri Cihaz Çözümleri: Hassasiyetten İnovasyona Elektronik ve optik sektörü, modern teknolojinin temel taşlarından biridir. Yarı iletkenlerden lazer sistemlerine, iletişim cihazlarından görüntüleme teknolojilerine kadar geniş bir yelpazede ürün ve uygulama alanı bulan bu sektör, sürekli yenilik ve yüksek hassasiyet gerektirir. Elektronik ve optik laboratuvarları, bu alandaki araştırmaların, prototiplemelerin, üretim süreçlerinin ve kalite kontrol faaliyetlerinin kalbi konumundadır. Labor İldam, bu dinamik ve talepkar sektördeki laboratuvarların ihtiyaç duyduğu son teknoloji laboratuvar cihazları ve entegre çözümler sunarak, inovasyon süreçlerinizi hızlandırır ve ürünlerinizin performansını optimize etmenize yardımcı olur.
 Kozmetik
Kozmetik Kozmetik Laboratuvarları İçin Gelişmiş Cihaz Çözümleri: Güzellikten Güvenliğe Kozmetik sektörü, cilt bakımından makyaja, saç ürünlerinden parfümlere kadar geniş bir ürün yelpazesini kapsayan, küresel çapta milyarlarca dolarlık bir endüstridir. Tüketicilerin güzellik ve kişisel bakım ürünlerine olan ilgisi arttıkça, bu ürünlerin güvenliği, etkinliği ve kalitesi daha da büyük önem kazanmaktadır. Kozmetik laboratuvarları, yeni formülasyonların geliştirilmesinden hammadde analizine, bitmiş ürünlerin kalite kontrolünden stabilite testlerine kadar pek çok kritik süreçte merkezi bir rol oynar. Labor İldam, bu dinamik ve rekabetçi sektördeki laboratuvarların ihtiyaç duyduğu son teknoloji laboratuvar cihazları ve entegre çözümler sunarak, inovasyon süreçlerinizi hızlandırır ve ürünlerinizin pazardaki başarısını destekler.
 Otomotiv
Otomotiv Otomotiv Laboratuvarları İçin İleri Cihaz Çözümleri: İnovasyondan Kaliteye Otomotiv sektörü, günümüz teknolojisinin ve mühendisliğinin en karmaşık ve dinamik alanlarından biridir. Yeni nesil araçların geliştirilmesi, elektrikli araç teknolojilerindeki ilerlemeler, otonom sürüş sistemleri ve artan çevresel düzenlemeler, otomotiv laboratuvarlarını sürekli olarak daha yenilikçi, daha hassas ve daha güvenilir analitik çözümler kullanmaya itmektedir. Malzeme karakterizasyonundan yakıt analizine, emisyon kontrolünden pil testlerine kadar geniş bir yelpazede kritik öneme sahip olan otomotiv laboratuvarları, sektörün geleceğini şekillendiren araştırmaların ve kalite güvencesinin merkezidir. Labor İldam, bu talepkar sektördeki laboratuvarların ihtiyaç duyduğu son teknoloji laboratuvar cihazları ve entegre çözümler sunarak, inovasyon süreçlerinizi hızlandırır ve ürünlerinizin performansını optimize etmenize yardımcı olur.
-
-
-
 Temsilcilikler
Temsilcilikler
-
Temsilcilikler
-
-
 Haier Biomedical
Haier Biomedical
-
 PHCBi
PHCBi
-
 Esco Scientific
Esco Scientific
-
 IC Biomedical
IC Biomedical
-
 Frimed
Frimed
-
 Nanoentek
Nanoentek
-
 Auguste Cryogenics
Auguste Cryogenics
-
 Steelco
Steelco
-
 Hettich
Hettich
-
 Macopharma
Macopharma
-
 Telstar
Telstar
-
 Miele Professional
Miele Professional
-
 Afi Groups
Afi Groups
-
 Raypa
Raypa
-
 Sherwood Scientific
Sherwood Scientific
-
 Terra Food- Tech
Terra Food- Tech
-
 Snijderlabs
Snijderlabs
-
 Saturix by FG Cleanwipes
Saturix by FG Cleanwipes
-
 Animal Care Systems
Animal Care Systems
-
 RWD Life Science
RWD Life Science
-
 Orchid Scientific
Orchid Scientific
-
 Esco Healthcare
Esco Healthcare
-
 Custom Biogenic Systems
Custom Biogenic Systems
-
 Puritan Medical Products
Puritan Medical Products
-
 Perfex
Perfex
-
 FinePCR
FinePCR
-
 Advanced Instruments
Advanced Instruments
-
 Medfor
Medfor
-
 Advantec
Advantec
-
 Sy-Lab
Sy-Lab
-
 Spermtech - Sperm Analysis Tecnologies S.L.
Spermtech - Sperm Analysis Tecnologies S.L.
 Haier Biomedical
Haier Biomedical Haier Biomedical, biyomedikal numuneler için düşük sıcaklık depolama ekipmanlarının araştırma ve geliştirme, üretim ve satışına odaklanmak üzere kurulmuştur. IoT kavramına dayanan şirket, yaşam bilimi ve tıbbi inovasyon alanında dijital senaryo çözümü sağlayıcısı haline gelmiştir. En iyi kullanıcı deneyimini yaratmayı hedefleyen şirket, esas olarak yaşam bilimi ve tıbbi inovasyon alanında faaliyet göstermekte ve hastaneler, biyofarmasötik işletmeler, üniversiteler ve kolejler, bilimsel araştırma kurumları, hastalık kontrol merkezleri ve kan istasyonları gibi çok çeşitli kullanıcı gruplarına akıllı laboratuvar, dijital hastane, akıllı halk sağlığı, akıllı kan kullanımı gibi birden fazla ürün ve hizmet kategorisini kapsayan kapsamlı dijital senaryo çözümleri sunmaktadır.
 PHCBi
PHCBi Labor ildam Laboratuvar Malzemeleri Tic. Ltd. Şti. ‘nin Türkiye distribütörlüğünü yaptığı Phcbi (Sanyo, Panasonic) 1990 yılında PHC Holdings Corporation ın bir yan kuruluşu olarak kurulmuştur, dünyadaki insanların sağlığını ve refahını iyileştirmek için kullanıcıların çalışmalarını destekleyen sürdürülebilir sağlık ve biyomedikal ürün çözümleri için lider, güvenilir bir marka olma hedefindedir. 25 yılı aşkın bir süredir ilaç, biyoteknoloji, hastane klinik ve endüstriyel müşterilerin ihtiyaçlarına cevap veren ve genel olarak bilimsel araştırmalara benzersiz bir bakış açısı sunan bir şirkettir. Türkiye distribütörlüğünü yapmakta olduğumuz PHCbi, dünya çapındaki uygulamalar için ürün geliştirmede kritik bir rol oynamakta ve yüksek kaliteli ve yenilikçi tıbbi ve laboratuvar ekipmanı üreticisi olarak ün salmıştır. Phcbi Avrupa nın önde gelen akademik ve araştırma enstitülerinin yanı sıra önde gelen ilaç, sağlık ve biyoteknoloji şirketleri ile uzun süreli ilişkiler kurulmuştur. Birçok açıdan standardı belirleyen bir şirkettir. VİP paneller, Cool Safe kompresörler, Aktif Arkaplan Kirlenme Kontrolü ve dünyanın ilk -152 C ULT dondurucusu. Uzun yıllardır Türkiye’de Labor İldam şirketiyle özdeşleşen Sanyo ve Panasonic markaları artık PHCbi adıyla pazarda varlığını devam ettirmektedir
 Esco Scientific
Esco Scientific Yaşam bilimi araçlarının dünya lideri üreticisi ve servis sağlayıcısı Esco Lifesciences, 100 den fazla ülkede çeşitlendirilmiş portföyü ve satışları ile dünya lideri bir yaşam bilimi şirketidir. Laboratuvar ve biyofarma ekipmanı ve IVF tıbbi cihazları üreticisi olarak Esco, çeşitli endüstrilerdeki laboratuvarların ihtiyaçlarına uygun özel çözümler sunar.
 IC Biomedical
IC Biomedical IC Biomedical, 66 yıllık soğuk zincir depolama ve taşıma teknolojisi mirasından yararlanarak kriyojenik ekipman pazarına yeni bir hayat getiriyor. IC Biomedical, küresel biyomedikal araştırma ve geliştirme, sağlık, biyodepo, ilaç, biyoteknoloji, IVF ve hayvancılık semen pazarları için en yüksek kalitede kriyojenik depolama ve taşıma sistemleri inşa ediyor.
 Frimed
Frimed Frimed, sahiplerinin tıbbi soğutma alanındaki yirmi yıllık deneyiminin sonucu olarak 1997 yılında kurulmuştur. Sürekli araştırma ve geliştirme, profesyonel ve ciddi tutumla birlikte Frimed'in hastane, endüstri, laboratuvar, biyomedikal ve ilaç alanlarında ve genel olarak bilimsel alanda kullanılmak üzere son derece güvenilir buzdolapları ve dondurucular tasarlamasını ve üretmesini sağlamıştır. Birkaç yıl içinde cihazlarımız iyi bilinir hale geldi ve artık dünyanın birçok ülkesinde takdir ediliyor ve tercih ediliyor.
 Nanoentek
Nanoentek POCT (Point Of Care Testing) alanında öncü! POCT alanında öncü, dünyanın en iyi mikroakışkan çiplerini geliştirme ve üretme teknolojisine sahip NanoEntek, 21. yüzyılın en gelişmiş teknolojisi olarak kabul edilen Mikro-elektro Mekanik Sistemler (MEMS) ile biyoteknolojiyi sorunsuz bir şekilde entegre eden önemli bir Biyo-MEMS teknolojisine sahiptir. Bu teknolojiyi hayata geçirmek için NanoEntek'in faaliyetleri, yaşam bilimleri laboratuvar ekipmanları, in vitro tanı tıbbi cihazları ve ilgili sarf malzemeleri ve çözümlerin Ar-Ge, üretim ve satışını kapsar. Şirketimizin Kore'de ve yurtdışında NT-IT-BT (nanoteknoloji-bilgi teknolojisi-biyoteknoloji) yakınsama teknolojisiyle ilgili yaklaşık 100 patenti bulunmaktadır. Özellikle, laboratuvar süreçlerini bir tırnak büyüklüğündeki bir mikroakışkan çip üzerinde entegre eden ve tıp ve yaşam bilimleri mühendisliği alanlarına önemli katkılarda bulunan lab-on-a-chip adlı önemli bir platform için teknolojiye sahibiz.
 Auguste Cryogenics
Auguste Cryogenics Slovakya'da bir üretim tesisi ve Almanya'da bir dağıtım merkezi bulunan Auguste Cryogenics grubunun bir üyesi olan "Auguste Cryogenics Slovakia s.r.o", kriyojenik depolama tanklarının üretim teknolojisi, tedariki ve inovasyonunda liderdir. Son derece profesyonel ve motive olmuş uzmanlardan oluşan bir ekibin çabaları sayesinde Auguste Cryogenics Slovakia s.r.o. güvenilirlik, kalite, yüksek düzeyde teknik uzmanlık ve "adil oyun"un eş anlamlısıdır. 2001'den beri Slovakya'nın Košice kentindeki üretim tesisi, ana hedefi dünya standartlarında kalite ve eksiksiz müşteri memnuniyeti olan ileri düzey bir Avrupa üreticisi ve yenilikçisi haline gelmiştir.
 Steelco
Steelco 2001 yılında İtalya'da kurulan ve 2017'den beri Miele Group'un bir parçası olan Steelco S.p.A., bugün sağlık, ilaç ve araştırma laboratuvarları için temizlik ve sterilizasyon sistemlerinin dünya çapında önde gelen üreticilerinden biridir. Sağlık koruma ve enfeksiyon kontrolünde bir ölçüt olan Steelco, müşterilerine giderek daha verimli ve güvenilir, otomatik ve sürdürülebilir, güvenlik seviyelerini en üst düzeye çıkaran, prosedürleri iyileştiren ve işletme maliyetlerini azaltan özel uçtan uca çözümler sunmaktadır.
 Hettich
Hettich Andreas Hettich GmbH, 120 yılı aşkın süredir küresel çapta kullanılan santrifüjler ve laboratuvar ekipmanları geliştirme ve üretme konusunda öncü konumdadır. 1904 yılında kurulan ve merkezi Almanya'nın Tuttlingen kentinde bulunan şirketimiz zengin ve dinamik bir tarihe sahiptir. Usta mekanikçi Andreas Hettich tarafından kurulan küçük bir atölyeden yola çıkarak, 500'ü aşkın çalışanı olan uluslararası üne sahip bir kuruluş haline geldik. Bugün, "Miras Gelecekle Buluşuyor" rehber ilkesi altında Tuttlingen'deki merkezimizden faaliyet göstermeye devam ediyor, tıbbi teknoloji alanında yeniliği teşvik ediyor ve yeni ölçütler belirliyoruz.
 Macopharma
Macopharma Macopharma, güçlü bir aidiyet duygusuna sahip bir aile şirketidir. Bir aileyi korumak ve herkesin büyümesini sağlamak için sağlam temellere sahip bir eve ihtiyacımız var: değerlerimiz. Evin bir çatıya da ihtiyacı var, bu bizim vizyonumuzdur, parlak ve anlamlı bir gelecek hedeflerken, günlük olarak misyonumuza güveniyoruz: hayatı destekliyoruz. Evimizin yol haritamızı temsil eden sağlam sütunları var: hayat, çözümler ve öğrenme Her Macopharma çalışanının bu evde bir yeri var Bu aynı zamanda paydaşlara da açık, bu yüzden birlikte daha güvenli ve daha sürdürülebilir bir kan endüstrisine katkıda bulunuyoruz. Macopharma Stratejik Evimizin her bölümünü keşfedin
 Telstar
Telstar GMP danışmanlığı, mühendislik ve inşaat projeleri ve entegre proses ekipmanlarının geliştirilmesinde uzmanlaşmış olarak, Yaşam ve Sağlık Bilimleri (ilaç ve biyoteknoloji, sağlık, kozmetik, veterinerlik ve gıda ve içecek endüstrileri) ile ilişkili şirketlere ve hastanelere, laboratuvarlara ve araştırma merkezlerine hizmet veriyoruz. Ayrıca, güç ve havacılık sektörlerindeki geleneksel ve yüksek teknoloji endüstrisi için vakum ve yüksek vakum teknolojileri ve büyük bilimsel deneyler için çözümler sunuyoruz. Tamamen entegre proses çözümleri Danışmanlık, mühendislik ve inşaattan entegre proses ekipmanlarına kadar yaşam bilimleri endüstrileri için karmaşık GMP projelerinin geliştirilmesinde 60 yılı aşkın deneyime ek olarak bilimsel ve havacılık sektörleri için gelişmiş çözümler sunuyoruz. Küresel vizyon ve tamamen sahip olunan uzmanlıkla.
 Miele Professional
Miele Professional Şirketimizin kuruluşundan bu yana Miele olarak bir inovasyon kültürü inşa ettiğimize inanıyoruz. Müşterilerimize katma değer sunmak ve en iyi çözümleri geliştirmek için birlikte çalışıyoruz. Üstün kalite ve uzmanlığı temsil eden güvenilir bir iş ortağı olarak dünya çapında rağbet görmekteyiz. Endüstriyel çözümlerimizle; bakımevlerinden itfaiye ekiplerine, hastanelerden anaokullarına, laboratuvarlardan çamaşırhanelere kadar uzanan birçok sektörü destekleyerek işletmeniz için bütünsel çözümler sunuyoruz.
 Afi Groups
Afi Groups Fransa'da üretilen laboratuvar ekipmanları FRANSA'daki Château-Gontier'de bulunan Fransız tasarım ve üretimi AFI santrifüjleri, klinik analiz ve biyomedikal araştırma laboratuvarlarının ihtiyaçlarını ve gereksinimlerini karşılamak üzere tasarlanmıştır. Çeşitli farklı rotorlar ve aksesuarlar sunan kullanıcı, temel biyolojik araştırmada kan örneklemesinden, tıbbi, farmasötik veya hücre kültüründen olsun, numunelerin ayrılması ve hazırlanması için tüm çözümlere sahip olacaktır. Havalandırmalı, soğutmalı versiyonda mevcut olan AFI santrifüjleri, piyasada bulunan tüm tüpler, şişeler ve mataralarla birlikte ve ayrıca mikro plakalarda numunelerin hazırlanması için kullanılmak üzere tasarlanmıştır. AFI santrifüjleri yelpazesi farklı Klinik, Endüstri ve Araştırma pazarını kapsar.
 Raypa
Raypa Uzman üretici, özgün tasarım, küresel marka 50 yılı aşkın deneyimiyle RAYPA, uluslararası ölçekte yenilikçi çözümler sunarak laboratuvar ekipmanı üretiminde küresel olarak tanınan bir lider olarak ortaya çıkmıştır. Odak noktamız otoklavlar ve gıda analiz ekipmanları için geliştirme, üretim, pazarlama ve satış sonrası hizmetler sunmaktır.
 Sherwood Scientific
Sherwood Scientific Sherwood Scientific'in geçmişi, öncül şirketlerimizden biri olan Evans Electroselenium Ltd.'nin kuruluşuna kadar 50 yıldan daha öncesine kadar uzanmaktadır. Bu şirket, 1930'ların sonlarında Arthur Evans tarafından kurulmuş ve selenyum fotosel uygulamalarının kullanılmasına dayanıyordu. Alev Fotometresi ve CHROMA Filtre Fotometreleri serisi bu kullanımın örnekleridir. Artık tamamı Cambridge'de üretilen Sherwood Scientific ürünleri, birkaç yıldır Corning ve CIBA Corning markalarıyla da ilişkilendirilmiştir. Johnson Matthey, Sherwood hikayesindeki bir diğer şirkettir. Johnson Matthey, değerli metaller sektöründe yoğun bir şekilde yer almaktadır ve Sherwood ürünlerinden ikisi, Akışkan Yataklı Kurutucu ve Manyetik Duyarlılık Terazileri, onların himayesinde geliştirilmiştir. Bu ürün serilerinin satın alınmasından bu yana, Sherwood Scientific bu ürünlerin birkaç yeni versiyonunu geliştirmiştir. Model 420, Dahili standarda sahip Çift kanallı bir Alev Fotometresidir ve Klinik ve Endüstriyel numuneler için mevcuttur. Ayrıca, geleneksel olarak kullanılan mevcut Lityum referans kanalına alternatif olarak Sezyum referans kanalıyla gelen Model 420Cs Alev Fotometresini de geliştirdik. Model 360, bir seferde bir elementin analizini sağlarken bakım kolaylığı için tasarlanmıştır. Rekabetçi bir fiyata sahip olan Model 360, standart olarak Sodyum, Potasyum, Lityum, Kalsiyum ve Baryum için beş filtreyle birlikte gelir. AUTO MSB, klasik Evans tasarımıyla aynı ölçüm prensibini kullanır ancak 200 kat daha hassastır. Sherwood, Johnson Matthey'den satın aldığı Tornado kurutucusuna hava akışı, giriş hava sıcaklığı ve kurutma süresinin Mikroişlemci kontrolünü ekledi ve Sherwood'un en son modeli olan Model 501 Akışkan Yataklı Kurutucu, partikül girişini önlemek için membranla kapatılmış kontrollere sahiptir ve ayrıca çalışma gürültüsünü azaltır.
 Terra Food- Tech
Terra Food- Tech Konserveler ve hazır yemekler için kompakt otoklavlar TERRA Food-Tech ® otoklavları, konserve, cam veya plastik ambalajlı gıdaları sterilize edebilir ve pastörize edebilir. Ürün numunesine yerleştirilen bir kalp sıcaklık probu kullanılarak ambalajlı gıdaların pişirilmesi, sterilizasyonu ve pastörizasyonu için tasarlanmıştır. Bu, organoleptik özellikleri korurken ve nihai ürünün besin özelliklerinde olası değişiklikleri en aza indirirken tüm sürecin mükemmel bir şekilde kontrol edilmesini sağlar.
 Snijderlabs
Snijderlabs 2008'den beri, yeni bir 'Snijders' nesli şirketin küreselleşmesini daha da ileriye taşıdı. Pieter ve Norman Snijders ekipleriyle birlikte yaklaşık 50 yıl önce sağlam bir şekilde atılan temelin üzerine daha da fazla inşa ettiler. 2013 yılında, Snijders satış faaliyetleri iki bölüme ayrıldı: Laboratuvarlar ve Bakım. Snijders Bakım, bakım kurumları ve hastanelerde dahili taşıma için lojistik çözümleri sunar. Snijders Laboratuvarları, laboratuvarlar için yüksek teknoloji depolama ve yetiştirme ekipmanları sunar. Snijders, tasarım ve üretim arasındaki kısa iletişim hatlarıyla her zaman kendini farklılaştırmıştır. Bu formülün etkili olduğu kanıtlanmıştır. Bu kısa hatlar ve kendi üretimimiz özel, kişiye özel siparişleri mümkün kılmaktadır. Kullanıcıların ihtiyaçlarını dikkatle dinlemek, Snijders'a şu anda gezindiğimiz ve ayarladığımız yenilikçi bilgi kazandırdı. Ve tabii ki, 60 çalışanımızın hepsine de teşekkür borçluyuz!
 Saturix by FG Cleanwipes
Saturix by FG Cleanwipes FG Clean Wipes'tan Saturix, tüm yüzeyler temiz odalar ve diğer kontrollü ortamlar için eksiksiz bir yüzey temizleme sistemidir. Son kullanıcılarımızın riski azaltmasına yardımcı olur, operasyonel verimliliği artırırken çalışan güvenliğini teşvik eder. Sistem, temiz oda mendilleri, temiz oda paspasları, yenilikçi paspas kovaları ve izolatör temizleme aracı, steril IPA ve diğer özel ürünlerden oluşan odaklanmış bir portföy içerir. 50 yılı aşkın temiz oda uzmanlığına sahip güvenilir bir ortak olarak FG Clean Wipes, dünya çapında en hassas, gelişmiş ve verimli çözümlerle her türlü özel veya özel etiket gereksinimini karşılayacak deneyime, kaynaklara ve ölçeğe sahiptir.
 Animal Care Systems
Animal Care Systems Animal Care Systems'ın benzersiz motorsuz atlıkarınca tasarımı en yüksek ve en ergonomik kafes yoğunluğunu sağlar. Mikro ortamlarımız gürültü, titreşim ve ultrason içermez. Patentli hava akışı sistemimiz, oda havasını kafesler ve raflar aracılığıyla doğrudan binanın HVAC egzoz sistemine yönlendirir ve filtreler. Bu sistem, barınma, deneyler ve üreme için ideal bir ortam sağlayan sakin, laminer bir hava akışı yaratır. Pasta şeklindeki kafesimiz 1997'den beri kemirgen yaşamını geliştiriyor. Animal Care Systems kafeslerinden elde edilen sonuçlar güvenilir, avantajlı ve sorunsuzdur.
 RWD Life Science
RWD Life Science Dünyanın önde gelen bilimsel ekipman üreticisi olan RWD Life Science (RWD olarak anılır), araştırmacılara yüksek kaliteli ve uygun maliyetli laboratuvar aletleri ve dünya çapındaki veterinerlere hayvan tıbbi ekipmanları sağlamaya kendini adamıştır. Ürün çözümleri hayvan cerrahisi ve modelleme, sinirbilim araştırması, hayvan davranışı araştırması, hücre ve moleküler biyoloji, mikrosirkülasyon izleme, patolojik tanı ve hayvan sağlığı alanlarından oluşmaktadır. Merkezi Çin'de bulunan ve ABD'de bir şubesi bulunan RWD, 2002'den bu yana 100'den fazla ülke ve bölgeye başarıyla ürün ve hizmet sağlamıştır. 6.000'den fazla üniversiteye, 1.000'den fazla araştırma enstitüsüne, 2.300'den fazla hastaneye ve 11.000'den fazla veteriner kliniğine hizmet verdik ve küresel müşterilerden sürekli güven ve destek kazandık. Geleceğe baktığımızda, kalite, dürüstlük, sorumluluk temel değerlerine bağlı kalacak ve klinik öncesi ve tıbbi klinik uygulamalarının ilerlemesine ve geliştirilmesine katkıda bulunacağız.
 Orchid Scientific
Orchid Scientific Yaşam Bilimleri Araştırma Endüstrisi: Buna önde gelen klinik öncesi, ilaç, biyoteknoloji ve akademik araştırma laboratuvarları dahildir. Adli Bilim Laboratuvarları: Adli bilim laboratuvarları için çözümler ve ekipman sağlıyoruz. Hayvan Barınma Laboratuvarı: Laboratuvar hayvan barınma tesisleri için ekipman sağlıyoruz. Araştırmacıların hedeflerine ulaşmalarına yardımcı olmak için her zaman temel araçları ve teknolojileri sağlamaya adanmış durumdayız. Yılların deneyimine, olağanüstü bir geçmişe ve müşterilerle uzun süreli ilişkilerimize sahibiz; bu da bizi operasyonların tüm yönlerinde mükemmelliğe ulaşmakla gururlandırıyor. Şirket en son teknolojik gelişmelerle güncel kalıyor ve müşterilerine yüksek performanslı çözümler sunmaya çalışıyor. Müşteri memnuniyeti ve büyüme bizim en büyük önceliğimizdir. Tutkulu ve öz motivasyonlu ekiplerimiz, müşterilerle iyi ilişkiler kurarak ve başarının anahtarına ulaşmak için onlarla yakın bir şekilde çalışarak her zaman müşterilerimiz için oradadır.
 Esco Healthcare
Esco Healthcare Esco Healthcare, temel platform ürünlerimizden uzman hizmetler, ekipman paketleri ve süreç çözümleri sunar. Bu, operatör korumasının iyileştirilmesine, çapraz kontaminasyonun azaltılmasına ve daha verimli işlemeye yol açar; böylece doğrudan ve dolaylı olarak mesleki sağlık ve insan sağlığı iyileştirilir.
 Custom Biogenic Systems
Custom Biogenic Systems Custom Biogenic Systems (CBS), 30 yılı aşkın süredir kriyojenik depolama çözümlerinin önde gelen sağlayıcısıdır. Şirket, kriyojenik depolamadaki yenilikçiliğiyle bilinir ve yaşam bilimlerindeki uzmanlığıyla saygı görür. CBS, güvenli ve verimli bir kriyojenik depolama yöntemi sağlayan kuru sıvı nitrojen teknolojisine sahip benzersiz İzotermal dondurucular da dahil olmak üzere gelişmiş kriyojenik ekipmanların geliştirilmesi ve üretiminde uzmanlaşmıştır.
 Puritan Medical Products
Puritan Medical Products America's Swab Experts Puritan Medical Products, dünya çapında en güvenilir swab üreticisi olarak bilinen bir Amerikan şirketidir. Ancak burada durmadık. Müşterilerimizin ihtiyaçları geliştikçe biz de geliştik. Bu, en zorlu uygulamalar için bile yenilikçi çözümler sunmak üzere en güncel malzemelerden ve üretim süreçlerinden yararlanan, sürekli genişleyen bir tıbbi ürün yelpazesiyle sonuçlandı.
 Perfex
Perfex Perfex'te, her gün güvendiğiniz temel temizlik araçlarını geliştirmenin yollarını her zaman arıyoruz. İlaç Üretimi Gıda ve İçecek İşleme Tesisler ve Bakım Paspaslama Sistemleri Süpürgeler ve Fırçalar Malzeme Taşıma Araçları Profesyonel destek ekibimiz, sanitasyon hedeflerinizi karşılamak ve aşmak için ideal ürünleri bulmanıza yardımcı olmak üzere eğitilmiştir. Bu tutku bizi sürekli hareket halinde tutar, başarılı olmak için ihtiyaç duyduğunuz temizlik araçlarını genişletir ve iyileştirir. Kritik Ortamlar İçin Temizlik Araçları
 FinePCR
FinePCR 1989 yılında kurulan FINEPCR, yaşam bilimleri için laboratuvar ekipmanlarında üretici olarak liderdir. Yolumuz boyunca istikrarlı bir şekilde büyüdük. Ve dünya çapında 30'dan fazla ülkede yaşam bilimi araştırma topluluğuna patentli mekanizma tarafından geliştirilen yüksek kaliteli cihazlar sağlıyoruz. Gelişen teknoloji ve yeni uygulamalardaki trendlere her zaman dikkat ediyoruz. Müşterilerimize iyi ürünler sunmak için sürekli olarak yeni cihazlar yaratıyor ve mevcut ürün yelpazemizi güncelliyoruz. Ayrıca iş ortaklarımıza mükemmel bir hizmet vermeye hazırız. Bu sadece taahhüdümüz değil aynı zamanda gururumuzdur.
 Advanced Instruments
Advanced Instruments Advanced Instruments, 2007 yılında Mart Microbiology'yi satın alarak anaerobik kavanoz sistemi Anoxomat® ile mikrobiyoloji segmentine giriş yaptı. Bu sistemin en son versiyonu olan Anoxomat® III, laboratuvarların mikrobiyoloji laboratuvarları için otomatik ve kolay bir şekilde tam ve tekrarlanabilir ortamlar oluşturmasına yardımcı olur.
 Medfor
Medfor 1971 yılında kurulan Medfor, analitik ve klinik kullanım için plastik numune kapları üretiminde uzmanlaşmış olup cama göre daha hafif, daha sağlam ve daha ucuz bir alternatif sunmaktadır. Ürünlerin çoğu, kapları çok çeşitli kombinasyonlar sağlamak için kapattığımız, etiketlediğimiz ve paketlediğimiz sınıf 10.000 temiz oda kullanılarak şirket içinde monte edilir. Ürünlerimiz, Birleşik Krallık ve diğer AB ülkelerindeki hastaneler, devlet kurumları, araştırma şirketleri, gıda ve genel endüstri tarafından kullanılmaktadır.
 Advantec
Advantec Gelecekteki Bilim İçin ADVANTEC Group üretimi Japonya'nın ilk filtre kağıdı işinden başladı ve sağlık, gıda, mikroelektronik ve enerji endüstrilerinde geniş bir yelpazede araştırma ve üretimi destekledi. Pazara daha iyi ürünler sunma hedefiyle işe başladığımızdan beri 100 yıl geçti. ADVANTEC Group, filtreleme teknolojimiz ve bilimsel ekipmanlarımız ile müşteri ihtiyaçlarına yanıt vermeye devam ediyor.
 Sy-Lab
Sy-Lab SY-LAB CRYO Sıvı Azot (LIN) Soğutma, Bilgisayar Kontrollü Oranlı Dondurucuların üretimi ve yüksek kaliteli numune depolama ve taşıma kaplarının (Sıvı Azot Dewars) dağıtımında 30 yılı aşkın deneyim, araştırma ve uygulama çözümlerindeki yetkinlik, SY-LAB'ı biyolojik derin sıcaklık depolamada ortağınız olarak nitelendirmektedir.
 Spermtech - Sperm Analysis Tecnologies S.L.
Spermtech - Sperm Analysis Tecnologies S.L. Çok çeşitli türler için seminal analiz cihazlarının geliştirilmesi, üretimi ve ticarileştirilmesinde 25 yılı aşkın deneyime sahip bir şirketiz. Hayvancılık, araştırma ve insan klinik tanısında yardımcı üreme teknikleri için yüksek kaliteli ürünler sunuyoruz.
-
-
Deney Hayvanları
Ürün Kategorileri
Açıklama
- Zorluk:
Sıcaklık, nem, ışık döngüsü, havalandırma gibi çevresel faktörlerin sabit
tutulması ve patojenlerden arındırılmış steril bir ortamın sağlanması.
- Çözümünüz:
Laboratuvarlarınıza sunduğumuz havalandırmalı kafes sistemleri (IVC),
otomatik su sistemleri, sterilizasyon ekipmanları (otoklavlar)
ve hassas iklimlendirme kontrol üniteleri ile deney hayvanlarınız
için optimal yaşam koşulları sağlayabilirsiniz. Bu cihazlar, hayvan refahı
standartlarına (örneğin GLP, AAALAC) uyumu garantilerken,
araştırmalarınızın tutarlılığını ve tekrarlanabilirliğini artırır.
- Zorluk:
Hayvan davranışlarını objektif ve tekrarlanabilir bir şekilde ölçmek,
karmaşık motor veya bilişsel görevleri değerlendirmek.
- Çözümünüz:
Şirketiniz, davranışsal test aparatları (örneğin, mazeler, açık alan
testleri) ve video izleme sistemleri gibi araçlarla davranışsal
çalışmaları destekler. Bu ekipmanlar, ilaç adaylarının merkezi sinir
sistemi üzerindeki etkilerini veya genetik modifikasyonların davranışsal
sonuçlarını objektif olarak değerlendirmenizi sağlar.
- Etik
Uyum ve Refah Odaklılık: Sunduğumuz tüm cihazlar,
hayvan refahı ve etik kurallar göz önünde bulundurularak tasarlanmış olup,
uluslararası düzenlemelere uyumu destekler.
- Yüksek
Hassasiyet ve Güvenilirlik: Araştırmalarınızın
geçerliliği için kritik olan, tekrarlanabilir ve doğru sonuçlar veren
yüksek performanslı cihazlar sunuyoruz.
- Kapsamlı
Çözüm Portföyü: Hayvan barındırma koşullarından ileri
analitik çalışmalara kadar deney hayvanları laboratuvarlarının tüm
ihtiyaçlarını karşılayacak geniş bir cihaz yelpazesine sahibiz.
- Teknik Destek ve Uygulama Uzmanlığı: Cihaz kurulumu, operatör eğitimi, periyodik bakım ve spesifik deney hayvanı modeli uygulamalarına yönelik metodoloji geliştirme konularında derinlemesine bilgiye sahip uzman ekibimizle sürekli destek sağlıyoruz.
Ürün Arama
Yükleniyor...